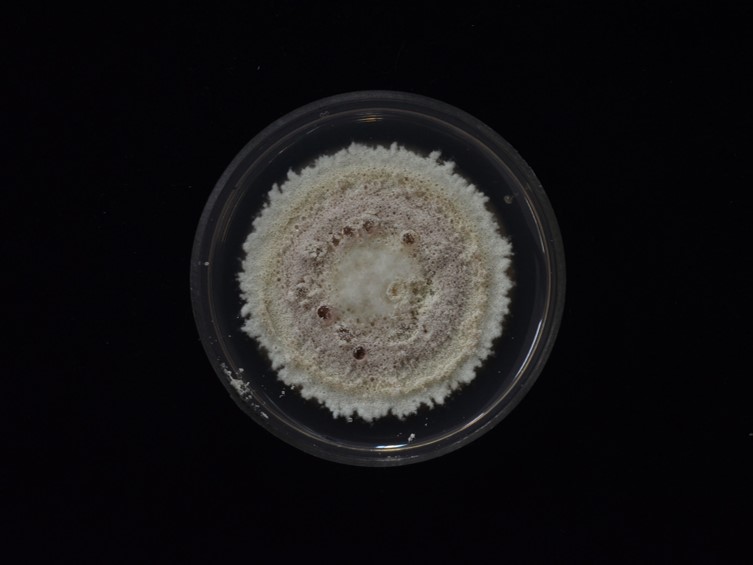

Holotype:
MALAWI, Zomba, 4 May. 1978, R.G. Pawsey, holotype IMI 228343.
Habitat:
Leaf litters.
Host:
Adult of insect in the order Hemiptera, Phoracantha semipunctata, stink bug, soils.
Description:
 Hosts covered with white mycelium, powdery when sporulating.Vegetative hyphae hyaline, septate, branced, smooth walls.
Hosts covered with white mycelium, powdery when sporulating.Vegetative hyphae hyaline, septate, branced, smooth walls.  Phialides hyaline, solitary, smooth-walled, ampulliform, subglobose, globose, ovoid, obpyriform, 2-5 × 1.5-3 μm.
Phialides hyaline, solitary, smooth-walled, ampulliform, subglobose, globose, ovoid, obpyriform, 2-5 × 1.5-3 μm.  Conidia hyaline, walls smooth, cylindrical, 2-5.5 × 1-2 μm.
Conidia hyaline, walls smooth, cylindrical, 2-5.5 × 1-2 μm.
Culture characteristics:
Colony on PDA dense, closely appressed and slightly convex to the agar surface, floccose, slightly accumulation of conidia, produced pinkish white pigment in agar medium, 28–32 mm diam in 10 d, 48–50 diam in 20 d.
Colony on PDA dense, closely appressed and slightly convex to the agar surface, floccose, slightly accumulation of conidia, produced pinkish white pigment in agar medium, 28–32 mm diam in 10 d, 48–50 diam in 20 d.
Reference:
Ariyawansa HA, Hyde KD, Jayasiri SC, et al. (2015). Fungal diversity notes 111–252—taxonomic and phylogenetic contributions to fungal taxa. Fungal Diversity 75: 27–274.
DOI: https://doi.org/10.1007/s11557-020-01557-9Khonsanit A, Luangsa-ard JJ, Thanakitpipattana D, et al. (2020). Cryptic diversity of the genus Beauveria with a new species from Thailand. Mycological Progress 19: 291–315.
Species |
Strain |
Compound |
Pubchem CID |
Biological activity |
Reference |
|---|
|
Strain |
Bloc | ITS | RPB1 | RPB2 | TEF1 |
|---|---|---|---|---|---|
| ARSEF 4755 | HQ880754 | HQ880825 | HQ880895 | HQ880967 | HQ881015 |
| ARSEF 7760 | HQ880756 | DQ376247 | HQ880897 | HQ880969 | DQ376246 |
| BCC 17613 | HQ880755 | HQ880824 | HQ880896 | HQ880968 | HQ881016 |
| BCC 20195 | MN401504 | MN401622 | MN401546 | MN401602 | MN401448 |